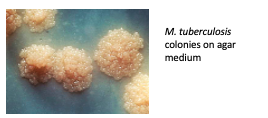

What is the envolope and cytoskeleton
what is the gram stain based off of

Morphological diversity in bacterial cells: What are tenericutes / Mollicutes
* known as naked or soft skin bacteria
* the mollicute Cytoplasmic Membrane is strengthened by addition of unique lipoproteins, glycolipids and glycoproteins
ex: genus Mycoplasma, Mycoplasma pneumoniae, and M. genitalium

pros and cons of mollicute
Pros:
Cons:
Cell walls on bacteria
*memorize the sugar names
what contains the peptido glycan layer
How is peptifoglycan unqiue to bacteria
describe the basic gram positive cell
components: Nucleoid (DNA), ribosomes, cytoplasm, cytoplasmic/plasma membrane, thick! (multiple layers) 20-80nm cell wall of peptidoglycan

what is streptococcus aureus
pros and cons of gram-psotive cell wall
Pros: strong, thick murein succulus, lipoteichoic acids and teichoic acids thread through it adding strength, protect against osmotic lysis, impart shpae to cell
*lipoteichoic acids and teichoic acids: long polysccaride chains unique to gram positive, extend away from surface of cell
Cons: must be protected from Lysozyme (will digest bond between 2 sugars on glycan)
examples of cell shapes of gram positive bacteris
*ake sure you know names to give examples of gram pos bacteria
what are mycobacteria
*bolded ones rae components unique to mycobacerial, memorize those

what components are unqiue to the mycobacterial cell wall
-Thick Arabinogalactan* layer and mycolic acids
what are mycobacteria resistant to?
desribe the basic gram negative cell
*periplasm = compartment between the CM and outer membrane, contains the thin PG

describe the gram-negative cell envelope-

what is LPS

pros and cons to gram negative cell
Pro
Cons
examples of gram negative bacteria
- Neisseria gonorrhoeae: coccoid-shaped
- Helicobacter pylori and Treponema pallidum (syphilis): helical/spiral shaped

bescribe the cytoskeleton of bacteria
what are the different shape determining cytoskeleton patterns?

what is the Surface layer

applications for S-layer in biotochnology
what are capsules
*bind water to form a hydration layer
functions: protection against immune system (resist phagocytosis, antibodies bound can easily be shed with the capsule), adherence, nutrient reserve and protects from dehydration
ex: Streptococcus and Rhizobium trifolii
